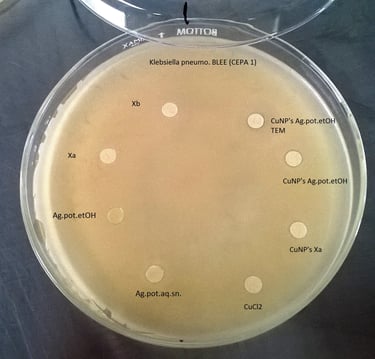
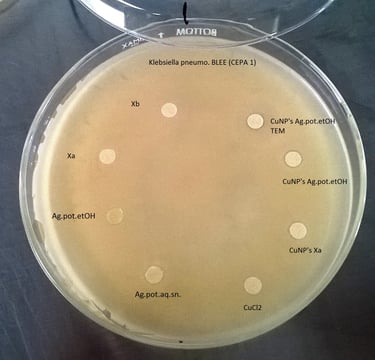

QUIENES SOMOS
Pasión por el cultivo
Hola, mi nombre es Bersain Moreno, he cultivado plantas de zonas áridas como cactus, caudex y suculentas durante 28 años hasta el día de hoy.
Químico Farmacobiólogo de profesión, hice una Maestría en Ciencias Microbiológicas por lo cual he manejado durante 20 años cultivos de microorganismos, como hongos y bacterias principalmente.
Así mismo trabajé 5 años como encargado de Banco de germoplasma de la Comisión Nacional Forestal, experimentando con diversos tipos de semillas ortodoxas y recalcitrantes.
Posteriormente realicé un Doctorado en Nanotecnología donde desarrollamos una nueva técnica mediante química verde para llevar a cabo la síntesis de nanomateriales metálicos, entre ellos nanopartículas de plata y oro, con diversas aplicaciones. (Quick synthesis of gold nanoparticles at low temperature, by using Agave potatorum extracts, Biosynthesis of gold nanoparticles from Agave potatorum extracts: effect of the solvent in the extraction)
La fusión de todo lo anterior me ha traído hasta aquí, para compartir la pasión, la técnica y el conocimiento para el cultivo de plantas de zonas áridas.
A lo largo de este recorrido he tenido que desarrollar soluciones para mejorar procesos como la recolección de semillas, almacenamiento de germoplasma y el cultivo de cactus y suculentas, para lograrlo he necesitado de accesorios o herramientas que no se encuentran disponibles en el mercado por lo cual he trabajado en el diseño de mis propios aditamentos y dispositivos, los cuales estoy seguro que pueden ser de interés y utilidad para las actividades que realizan otros apasionados y profesionales en la propagación y cultivo de plantas de zonas áridas. Bajo este concepto innovador estamos desarrollando un sistema nanotecnológico de protección de germoplasma denominado Nanosilver Germplasm Protection, con la finalidad de mantener el germoplasma colectado en forma de semillas en las mejores condiciones posibles por largos periodos de tiempo.
Sean bienvenidos a la experiencia del Aridarium, cultivos legendarios.
Bersain Moreno

¡Conecta con nosotros! #CultivosLegendarios
CONÓCENOS
Cultivos legendarios, Experiencia y Pasión por el cultivo
El Aridarium, cultivos legendarios es una empresa que desarrolla soluciones para mejorar la experiencia de cultivo de plantas de zonas áridas y suculentas.
Nos comprometemos en proporcionar la mejor calidad de productos a nuestros clientes, por el momento no somos proveedores de plantas o semillas.
Nuestros accesorios son elaborados con los materiales más resistentes, estamos creando productos innovadores y de gran utilidad especialmente diseñados para el cultivo de plantas de zonas áridas.










Misión: Inspirar a las personas a desarrollar sus habilidades de cultivo proporcionándoles herramientas y productos innovadores de calidad para enriquecer su experiencia en el mantenimiento de sus plantas suculentas y de zonas áridas.
Visión: ser una empresa líder en el desarrollo de productos innovadores para los profesionales y apasionados en el arte del cultivo de plantas suculentas y de zonas áridas.

Aspectos reelevantes sobre el cultivo de plantas de zonas áridas
El cultivo de cactus y suculentas presenta retos particulares que surgen de las condiciones especiales que enfrentan estas plantas en la naturaleza, para lo cual han desarrollado mecanismos y estrategias que les proporcionan resistencia contra las difíciles condiciones ambientales de su medio, estas estrategias les permiten sobrevivir en entornos hóstiles durante las temporadas de sequía, como la presencia de tejidos especializados en el almacenamiento de agua.
Este modo de vida particular que han adquirido genera desafíos específicos que en muchas ocasiones son subestimados por el cultivador aficionado, resultando en el desarrollo de plantas débiles o enfermas que en cualquier momento pueden sucumbir irreversiblemente hacia su muerte. Por ello para lograr un mejor cultivo de estas especies de zonas áridas los factores principales que se deben tomar en cuenta en sus condiciones diarias según la experiencia que he adquirido en su cultivo son:
Tipo, material y tamaño de contenedor utilizado
Tipo de sustrato utilizado
Horas de luz e intensidad de luz que recibirá la planta
Rangos de temperatura
Régimen de riego
Tamaño y edad de la planta
Cada uno de estos factores debe considerarse para lograr el cultivo exitoso de este tipo de plantas especializadas en crecer en zonas áridas.
Y todo comienza, por la correcta colecta, tratamiento y almacenaje del germoplasma.












Cultivos legendarios, Experiencia y Pasión por el cultivo







Astrophytum ornatum



Mammillaria pectinifera



Astrophytum myriostigma













Lo que dicen nuestros compradores...
”Mi experiencia con las herramientas de Aridarium ha sido de lo mejor. Me ha facilitado mucho el cuidado de las plantas. Principalmente las raíces al momento de sembrar o trasplantar de maceta. Muy fáciles de maniobrar, resistentes y de limpieza fácil. .”
- Daniel Vite
”Bonitas, funcionales y muy resistentes! Sin importar tu nivel de experiencia, son exactamente lo que buscar para facilitar tu trabajo. El que las fabrica sabe lo que necesita un cultivador de cactus y suculentas.”
- Gandhy Salgado
”Las herramientas son útiles y funcionales, se sienten cómodas y avanzo rápidamente en el cultivo de mis cactus"
- José Sanchez
”Me gustó que los materiales son robustos y los terminados son bastante buenos, apenas voy comenzando en el cultivo de plantas suculentas pero estas herramienta me están ayudando mucho"
- Juan Martínez
”El Kit de herramientas del Aridarium son excelentes, a mi me han facilitado mucho las maniobras con respecto al cultivo y trasplante, incluso las utilizo también para mis orquídeas minis. Un gran acierto su adquisición.”
- Lourdes
”Bastante interesante la manera de guardar semillas por bastante tiempo, sin tener perdidas por humedad, problema que ya había tenido antes. Es muy práctico y útil el sistema de recolección de frutos y semillas del Aridarium, lo recomiendo bastante..”
- David


























